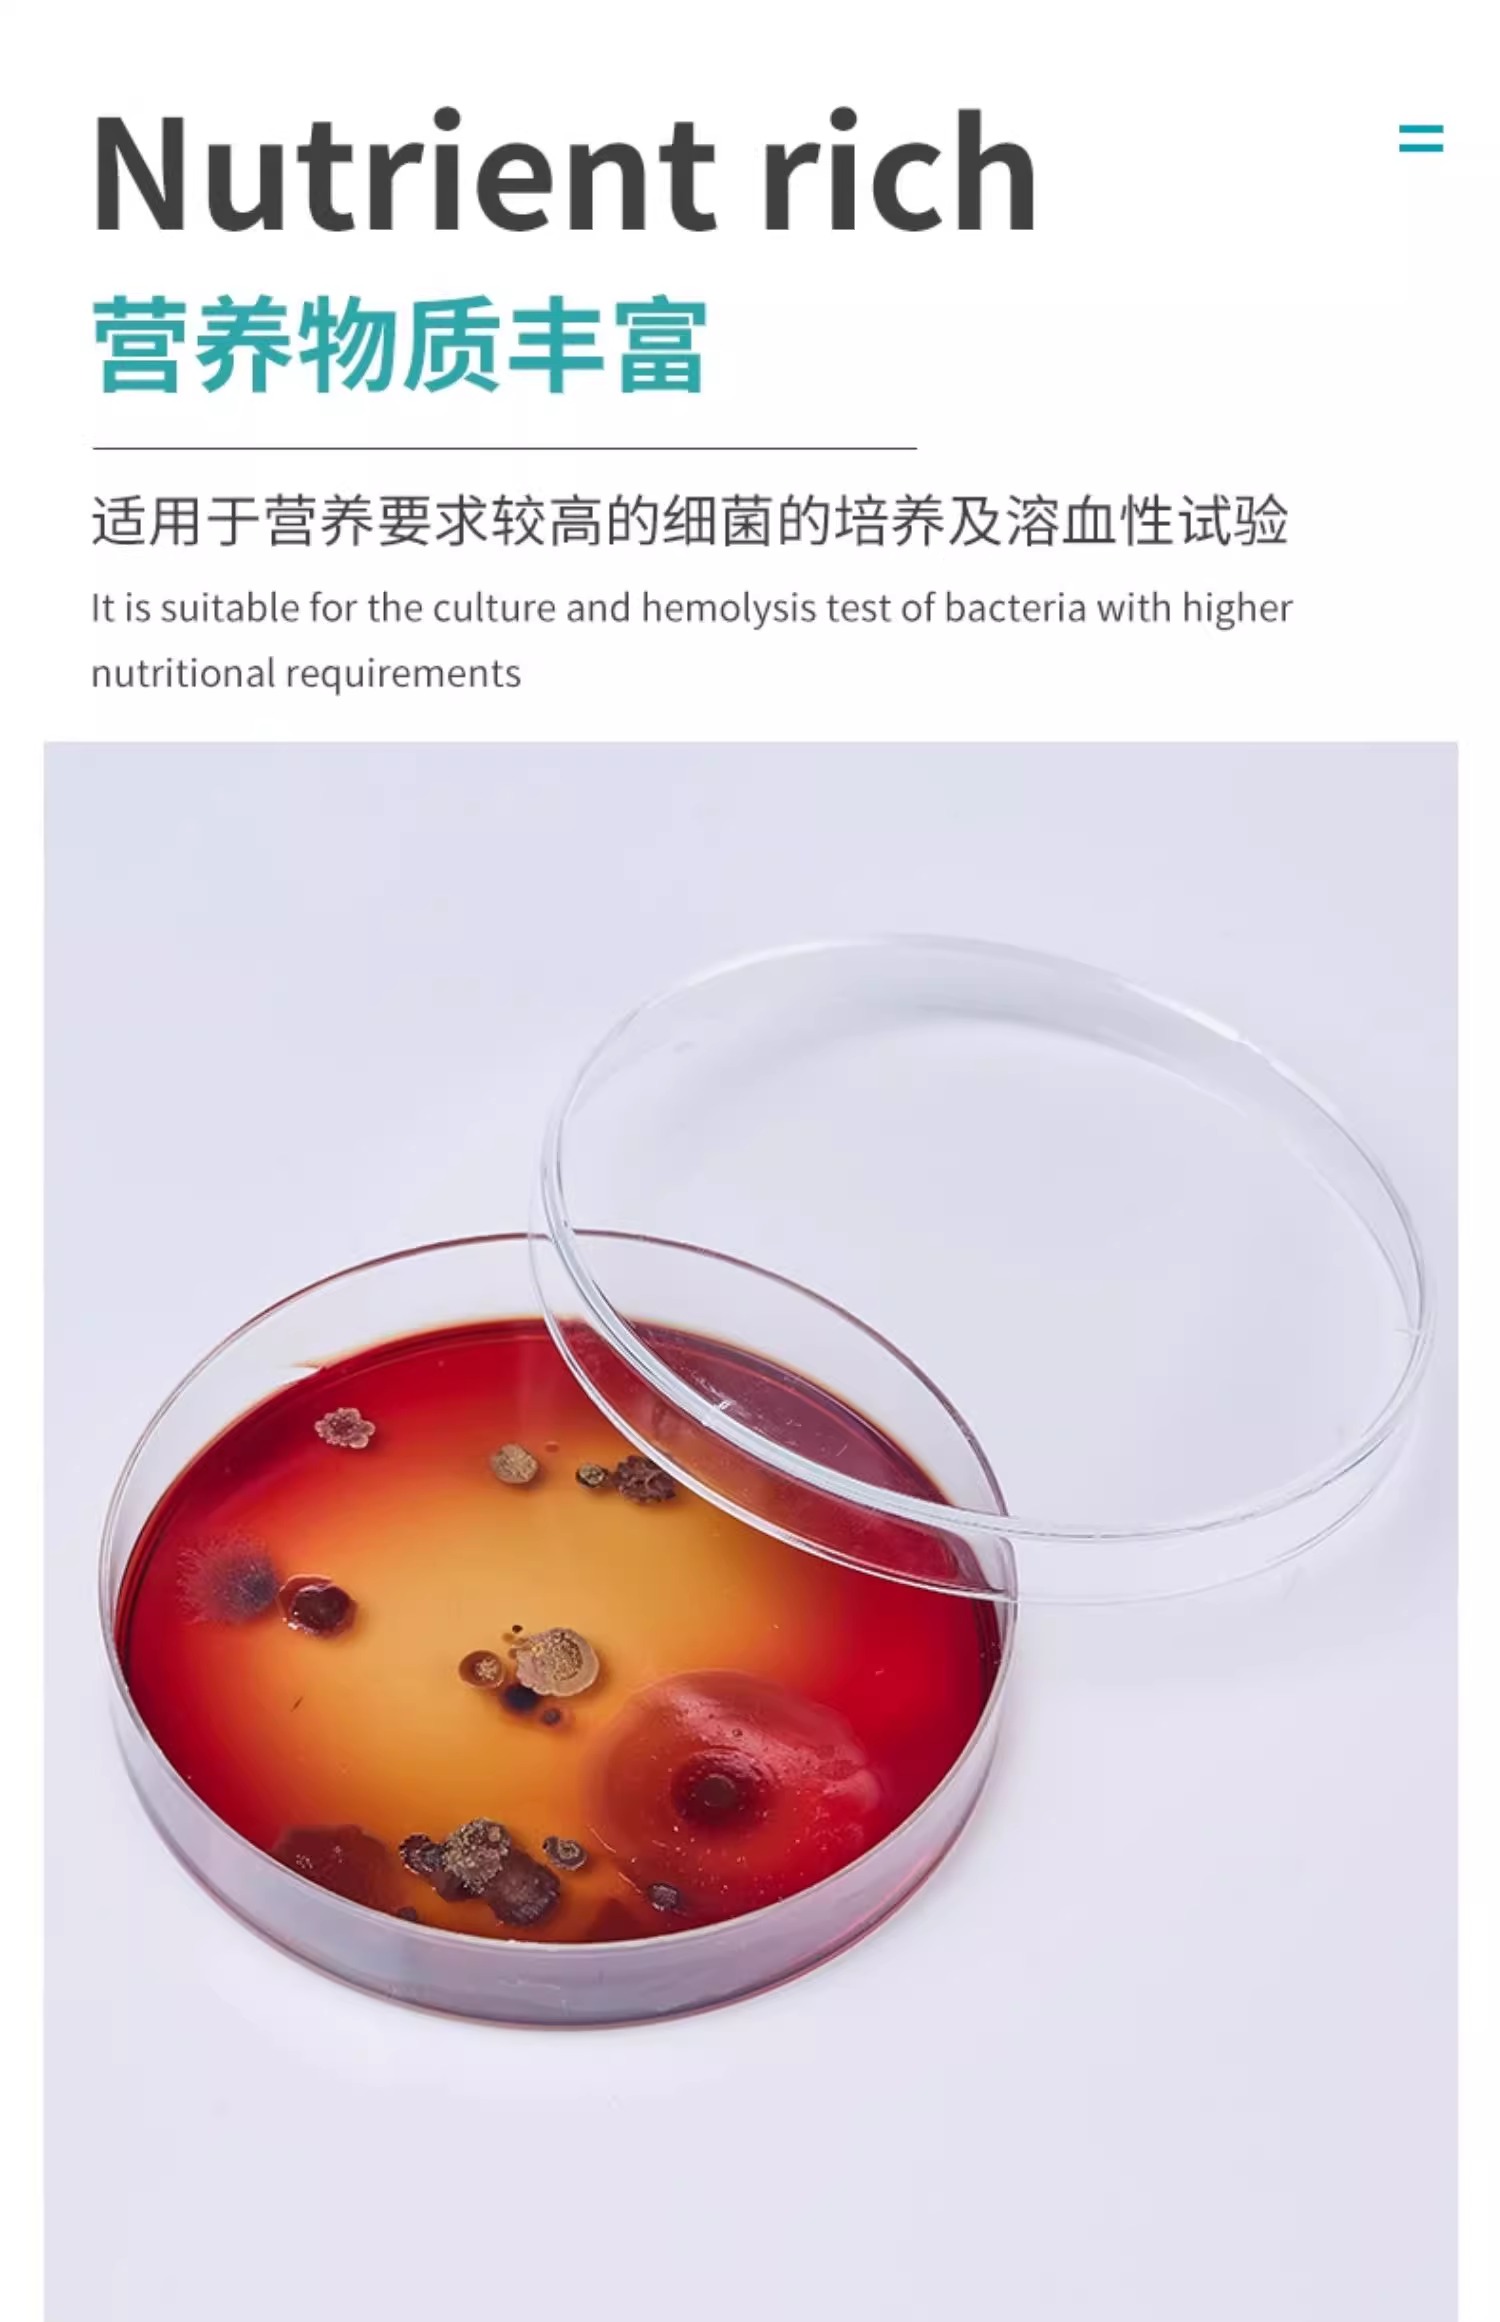
11.jpg

中文版
English
加入收藏
血瓊脂平板
產(chǎn)品名稱:血瓊脂平板
產(chǎn)品品牌:BKMAMLAB
產(chǎn)品規(guī)格:
-
9cm 110704011